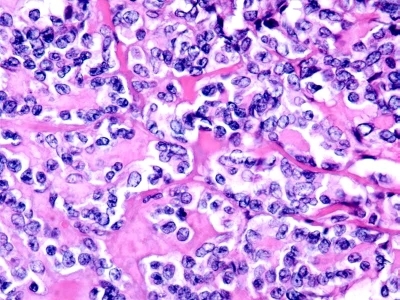
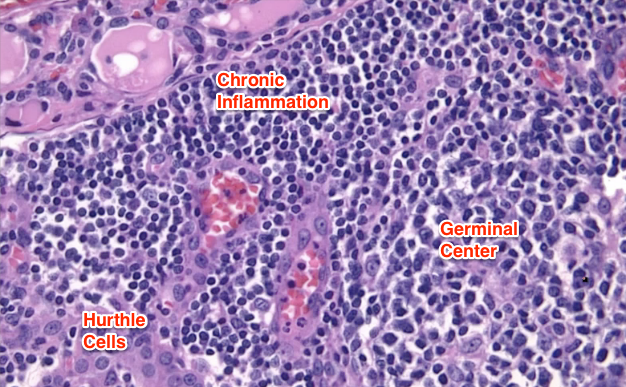

Things to ask a patient in the H&P with a solitary asymptomatic thyroid nodule
Radiation hx (10-25 years ago, low-dose = 40% risk w/papillary being the most common), voice and airway sx and pattern of nodule growth.
Next step in a patient with a painless solitary thyroid nodule and hx of neck radiation
Proceed directly to thyroidectomy if the nodule is hard, fixed and the patient has associated dyspnea, hoarseness or cervical LN enlargement. If it is less likely to be malignant do FNA.
What type of thyroid cancer has a strong autosomal dominant inheritance pattern and is often seen in families? How can you screen for it?
Medullary thyroid carcinoma can be due to autosomal dominant mutation of the RET protoncogene and is involved in MEN2a (+ pheo + parathyroid) and MEN2b (+ marginoid w/mucosal neuromas + pheo). You can screen for this by looking for high levels of calcitonin.
In addition to FNA, what other tests can be useful in working up a patient with suspected thyroid cancer.
Radioactive scan for hot vs. cold nodules, u/s to determine if cystic and TSH levels are all appropriate after getting path results from the FNA.
Tx for a colloid nodule dx by thyroid FNA

Thyroid suppression only
Tx for this dx by thyroid FNA

Note the orphan Annie nuclei indicating papillary thyroid carcinoma, they also sometimes have Psammoma bodies. This patient needs total thyroidectomy if > 1.5 cm or PHMx is + for neck radiation. Limited thyroid lobectomy and isthmusectomy can be done in patients with no hx of neck radiation. Both surgeries can have +/- berry picking LNs. Finish off w/thyroid hormone suppression +/- I-131 ablation

Tx for this dx by thyroid FNA
Medullary thyroid carcinoma due to proliferation of C cells (parafollicular cells) is highly malignant and needs total thyroidectomy +/- central and lateral neck node dissection, +/- neck irradiation. Note the amyloid deposits that stain due to high production of calcitonin.
Tx for this patient in his 7th decade with this dx on thyroid FNA

Anaplastic carcinoma has +LNs 50% of the time, distant mets 30% of the time (lung most common) and an extremely poor prognosis. Tx for anaplastic thyroid cancer is chemorads +/- surgical salvage operation w/wide excision
Tx for this dx on thyroid FNA
Note the Hurthle cells, indicating possible Hashimoto thyroiditis or adenoma. Note that you cannot make a definitive dx of Hurthle cell or follicular carcinoma (shown below) on FNA and lobectomy is appropriate with total thyroidectomy if cancer is present. If thyroiditis, hormone replacement alone is fine.

What are the risks of thyroidectomy?
Always bleeding/infection. Injury to unilateral recurrent laryngeal nerve = hoarsenss. Injury to bilateral recurrent laryngeal nerves = cord paralysis and tracheostomy. Injury to superior laryngeal nerve = loss of high pitch singing voice. Loss of parathyroids = hypocalcemia.

A patient presents after biopsy of a thyroid nodule with the image below. How do you manage this patient?

Follicular cancer, which is more prevalent in I-deficient areas, can be treated with lobectomy and isthmusectomy. Total thyroidectomy is indicated if > 4cm. If frozen section shows clear dx of follicular cancer total thyroidectomy is warranted if > 1cm.
Prognostic indicators for papillary cancer
“AGES”: age > 40, higher grade, extensive disease and large size are all poor indicators. 10 year survival in low risk pts is ~ 100%. In high risk patient ~20%.
Post-op surveillance in a patient with thyroidectomy and LN dissection due to medullary thyroid cancer
Serum calcitonin and CEA can be useful markers for indicating recurrence. If the patient had LN involvement 10 year survival is 45%, so you really need to be on the lookout for these guys as opposed to those who had local disease with a 10 year survival of 80%.
Lab indicators of primary hyperparathyroidism
Elevated PTH and elevated serum Ca
What does this patient with hyperparathyroidism present with?

Osteitis fibrosa cystica
Most common cause of primary hyperparathyroidism
Parathyroid adenomas followed by parathyroid hyperplasia. Parathyroid carcinoma is preset in < 2% of cases

Common presenting sx of hyperparathyroidism
Muscle weakness, myalgia, arthralgia, nephrolithiasis, constipation, polyuria, psych disorders and PUD…i.e. painful bone, kidney stones, abdominal groans and psychiatric overtones.

Surgical management of parathyroid adenomas
Find all 4, sample them to make sure the ones you leave in are normal and take out the adenoma. If you can’t find all 4, you need to close and order sestamibi scan, MRI, CIT, u/s, angiography or venous sampling to find the missing parathyroid. Once you find it, you can re-explore and take it out.
What are common locations for ectopic parathyroid glands?
Most common location for a missing inferior gland is in the thymus due to migration with it from the 3rd pharyngeal pouch during embryogenesis. Tx w/thymectomy. Other common locations include intrathyroidal, in the tracheoesophageal greoove (especially ectopic supernumerary glands), carotid sheath and intravagal.

Complications of parathyroidectomy
Same as thyroidectomy + risk of hypocalcemia (tetany, + Chvostek) and hyperphosphatemia if you remove all of the glands.
When do most surgeons recommend parathyroid exploration for asymptomatic hypercalcemia?
Serum Ca > 11
Where do the superior parathyroids come from?
4th pharyngeal pouch w/the thyroid gland

Common causes of acute hypercalcemia
Parathyroid adenoma (increased PTH), metastatic breast carinoma (osteolytic), multiple myeloma (activates osteoclasts), hyperthyroidism (T3 increases bone resorption), sarcoidosis (macrophages make 1,25-OH-D3), milk alkali syndrome (increased ingestion of Ca-carbonate = alkalosis = decreased Ca renal excretion), vitamin A intoxication (increases bone resorption by IL-6), thiazides (Ca-sparing diuretic), renal cell carcinoma (PTHrP, IL-6, osteolysis), lung SCC (PTHrP) and familial hypocalciuric hypercalcemia (loss of Ca-sensing receptor in parathyroids and kidneys).
Acute tx for hypercalcemia
Hypercalcemia causes osmotic diuresis, resulting in fluid depletion and increasing serum [Ca]. Tx initially w/IVFs, furosemide to increase Ca excretion, bisphosphonates and then go for the underlying cause. Long term you can use mithramycin, calcitonin and glucocorticoids to lower Ca levels.